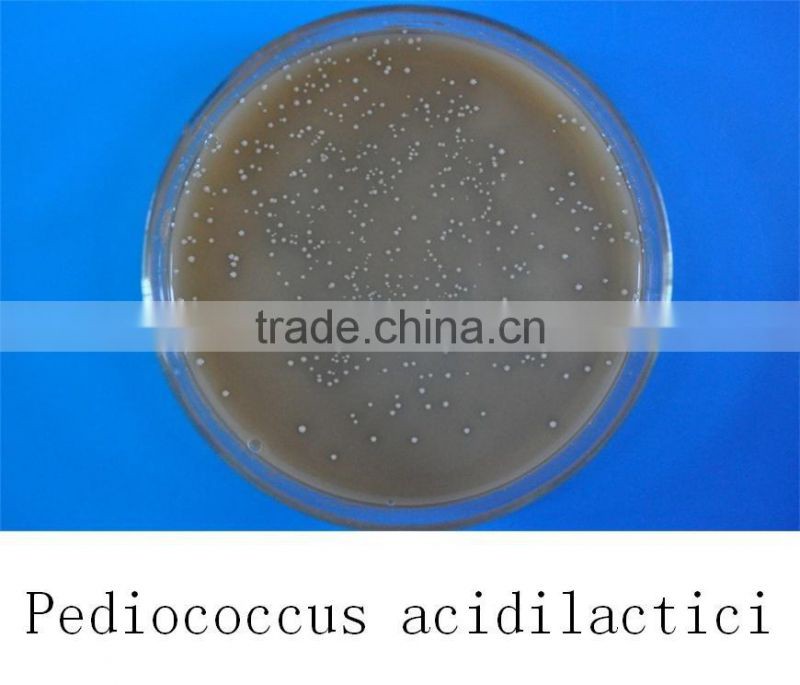
Probiotics feed additive pediococcus acidilactici

Welcome!





| Type | Feed Grade Microecologics | ||||
|---|---|---|---|---|---|
Pediococcus Acidilactici

Main element:
Pediococcus acidilactici, fermentation metabolites.
Appearance:
Powder
Concentration:
a. Improve the functions of the gastrointestinal tract and the digestibility of the feed; inhibit the growing of putrefactive bacteria; enhance the immunity.
b. Balance the intestinal flora, produce the benefit metabolite, activate the activity of the acid protease.
c. Reduce the levels of serum and total cholesterol, control the endotoxin.
Storage:
Put it in a cool, dry and shady place.
Shelf life:
18 months.
We are manufacturer in producing probiotics for 20years, let me show you our factory.
Our south factory zone

Our north factory zone

Our production equipment

Our R&D laboratory

Our warehouse and storage

Our honours and certifications

We promise all of our products are with best quality and reasonable price
Contact Us
Cangzhou Tianrunwanwu Biotechnology Co., Ltd.